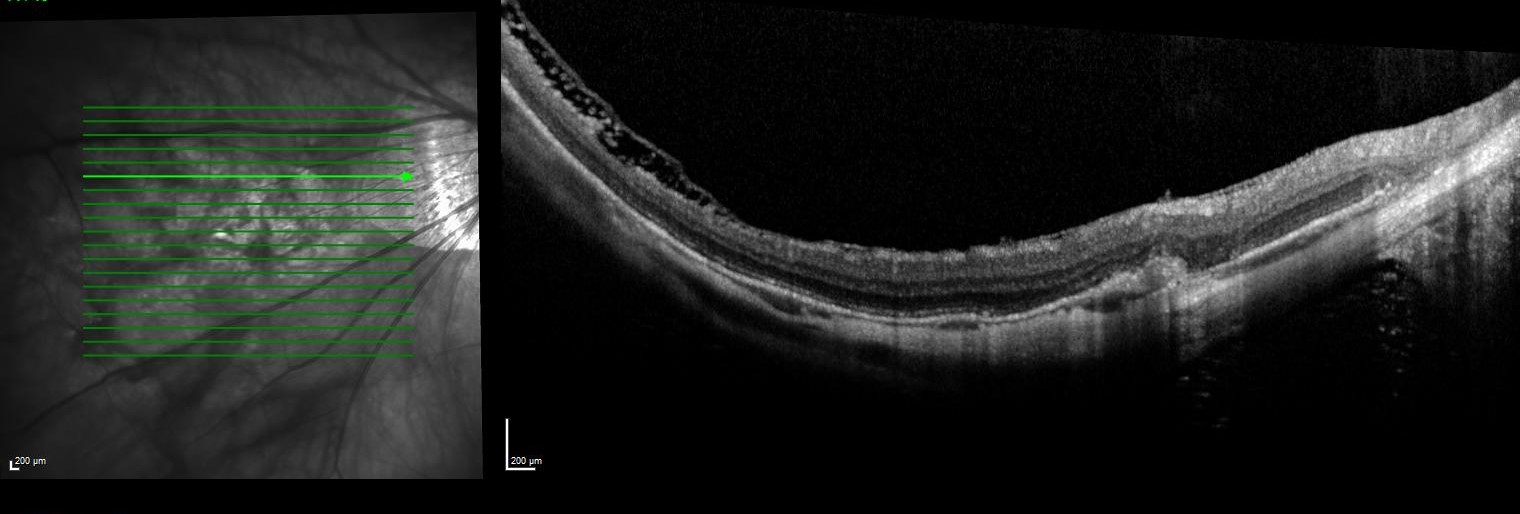

These days, more of our keratoconic patients are demanding improved levels of vision so that they may go about their days unhindered by blur and distortion. This is especially true in someone with monocular corneal disease, as these patients typically have a fellow eye with excellent vision, enabling sometimes unfair comparison. Fortunately with technological updates to contact lens technology, excellent vision is obtainable especially in patients with only mild to moderate levels of corneal ectasia and clear ocular media. This case describes how troublesome residual astigmatism in a non-rotationally symmetrical scleral lens can be alleviated with the use of a toric front optic-zone in a patient with moderate monocular keratoconus.
The patient in question, a male in his mid 20s, presented to our practice after living in another part of the country for several years. He has an interesting case of monocular keratoconus in his left eye and has worn a KATT scleral lens from Capricornia in the past. However he lost this lens a year prior and has been getting by with using a spherical monthly silicone hydrogel lens to correct the low myopia in his normal right eye.
Refraction was R -2.00/-0.25 x 90 (6/5), L -1.25/-6.50 x 132 (6/20+). Corneal topography revealed an essentially normal pattern in the right eye and a steep central area with surprisingly regular astigmatism in the left eye. Keratoconus was confirmed with pachymetry showing relative thinning in the left eye: R 562µm, L 530µm. Slit-lamp examination revealed no corneal opacity in either eye.

Axial maps of the right and left eye showing the significant curvature difference between the two eyes.
Trial-fitting with the Eyespace Scleral lens was carried out with the aid of anterior OCT to assess central clearance and landing zone alignment. Despite his large corneal diameter (HVID) the lens size of 16.5mm was chosen as the larger 17.5mm size decentered inferiorly following insertion. This also matched the size of the KATT lens he has used in the past. I always assess flexure of the lens with over-topography during trial fitting as this gives me an idea of the level of scleral toricity. The Scleral Shape Study from Pacific University showed us that the majority of sclera are asymmetrical and tend to be flatter in the nasal aspect. Fitting a spherical scleral lens to an asymmetrical sclera often results in lens flexure, leading to residual astigmatism. In moderate-severe cases it can also cause the lens to be unstable on the eye.
There are different schools of thought in scleral lens circles about how to deal with flex. Traditionally lenses were just made thicker to nullify the tendency to bend. However as shown by Michaud et al 2012 thicker lenses decrease the transmission of oxygen to the cornea. This means that theoretically only lenses with a thickness of 250µm and low clearance of 100µm satisfy the Holden-Mertz criteria for a material with a Dk of 100. It follows that trying to keep the lens thickness to a minimum is sensible.
In my view a more elegant way to control flex is by using a lens with a higher sagittal height in the steep meridian (much like a toric-periphery corneal lens), thus evenly distributing the bearing of the peripheral scleral landing zone. A rule-of-thumb to estimate the degree of sagittal difference is 200µm for every diopter of flex found with corneal topography. Of course some may point out that a thick spherical lens that does not flex may promote more tear exchange behind the lens, however that is a discussion for another day.
Clinically, I find that most eyes that I fit with a scleral lens require a toric periphery to eliminate residual astigmatism and best stabilise the lens. Eef van der Worp’s excellent review of scleral lenses (now in it’s second edition and free to download from Pacific University) also comments that longer wearing time and better comfort is evident in well-fitted back surface designs.

Anterior OCT of the lens showing 160µm of central clearance and well-aligned base curve
OCT of the inferior scleral landing zone showing limbal clearance and well-aligned landing angle
Using the data from the trial fitting process the patient’s first custom lens was designed with 200µm of sagittal difference between meridians and a spherical base curve and power of 7.8mm and -3.50D respectively. On delivery the lens had even scleral alignment and after settling 160µm of central clearance. The lens was quick to align with the ‘flat’ meridian’s marking along 30 degrees, matching the principal meridians of flexure on the over-topography of the trial lens.

Slit-lamp images of the lateral landing areas of the scleral lens showing the marking indicating the ‘flat’ meridian of the lens at 30 degrees
Vision however was only 6/12, improving significantly with refraction of plano / -1.25 x 85. No flexure was seen in this lens and no significant spherical aberration was present with retinoscopy. As the axis of lens stabilisation and residual astigmatism did not match up it is unlikely that modification of the peripheral lens parameters would assist here. Instead it was decided to incorporate front-surface toricity to correct the residual astigmatism.
There are several ways to stabilise the rotation of a front surface toric scleral lens including double slab off prism (superior and inferior thin zones), inferior prism ballast and use of pinguculae notching. These techniques typically rely on a patient inserting the lens with the correct orientation (a nightmare for many visually-handicapped keratoconics) and in the cases I have witnessed, may still rotate during wear. The beauty of using a lens with a toric periphery is that, like a toric soft contact lens, the patient can insert the lens at any orientation and it will quickly rotate into the correct position.
A new lens was ordered with a power of -3.50 / -1.25 x 55 and otherwise identical parameters. After delivery the lens once again rotated to 30 degrees, bringing the axis of the front optic zone neatly to 85 degrees - the exact axis of the initial lens’ residual astigmatism.

Axial over-topography of the final front-surface toric lens, nicely showing the -1.25D of astigmatic correction incorporated sitting with axis of 85
Vision in this eye had now improved to 6/5 and no residual refraction was found. The patient commented this was the best quality of vision he had seen with his left eye, and pleasingly noted similar acuity when compared to his right eye (now refitted into a -2.00D daily).
Stay tuned for the next edition of Specialty Contact Lens forum where I will discuss a case of large diameter scleral lens for the management of debilitating dry eye. This case can be found online, along with other specialty lens reports, at www.eyespace.com.au/blog.
About the author
Alex Petty is a Kiwi optometrist who graduated from the University of Auckland in 2010. He has an interest in specialty contact lenses, ortho-K and silmoparis.com myopia control.